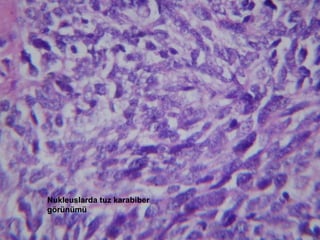
Nukleuslarda tuz karabiber görünümü

More Related Content
PPS
Karaciğer patoloji pratik e4 b2(byramazankaya)2 PPTX
e3b1 Patoloji by ramazan kaya Tipciyiz.Biz PPT
PPT
Solunum sistemi patolojisi (1) PPT
Lenfoid sistem patolojisi (3) PPT
3)deri patolojisi pratik 2015 PPTX
Solunum sistemi histolojisi PPT
e4b3 patoloji pratik sınavı sunumları | byramazankaya http://www.tipciyiz.biz Viewers also liked
PPT
PDF
PPTX
PPT
Respiratory Distress Syndrome (Rds) PPT
KİŞİLER ARASI İLİŞKİLERDE ÇATIŞMA VE ÇATIŞMA ÇÖZME PPT
Similar to 1 e4 b1 pratik
PPT
E4 b1 patoloji pratik videolardan notlar PPT
Hemoptizi (fazlası için www.tipfakultesi.org ) PPT
PPT
Ust solunum-yolu-hastaliklari PPT
Restriktif akc hst (fazlası için www.tipfakultesi.org ) PPTX
PPTX
PPTX
Toraks bt tanı görüntü anlama ve egitimi PPT
PPTX
PPT
Akciğer grafisi (fazlası için www.tipfakultesi.org) PPT
PPT
PNÖMONİLER (fazlası için www.tipfakultesi.org ) PPTX
akciger enfeksiyonları (fazlası için www.tipfakultesi.org ) PPT
Obstruktif akc hst (fazlası için www.tipfakultesi.org ) PPT
PPTX
paranasal sinüs tm aproacfffaklaşım.pptx PPTX
paranazal sinüs tümörlerine yaklaşım.pptx PPT
Hepatosplenomegalisi olan cocuga yaklasim PPTX
Renal Hücreli Kansere Bağlı Multiple Akciğer Embolisi Vakası More from Tipciyiz Biz
PPS
Gastro patoloji pratik e4 b2(byramazankaya)1 PPS
Endokrin patoloji pratik e4 b2(byramazankaya)4 PPS
Pankreas ve biliyer sistem patoloji pratik e4 b2(byramazankaya)3 PPTX
4 patoloji pratik e4 b1(ramco) PPT
PPTX
4 patoloji pratik e4 b1(ramco) PPT
Funda yılmaz pratik cvs 2010 2011 PPT
PPT
2b funda yılmaz pratik cvs 2010 2011 PPT
2a dolaşım pratik 2010 deniz nart PPTX
4 patoloji pratik e4 b1(byramazankaya) PPSX
Parazitoloji pratik-sınavı-e3b1-eutf-tipciyiz-biz-ramazan-kaya PPTX
E4 b4 patoloji_pratik-tipciyizbiz-ramazankaya XLS
XLS
XLS
PPT
PPS
PPS
1 e4 b1 pratik
- 1.
- 2.
- 3.
- 4.
LARİNGEAL NODÜL Üzerinormal çok katlı yassı epitelle örtülü, subepitelyal bölgede hyalinizasyon gösteren nodül - 5.
- 6.
- 7.
- 8.
- 9.
- 10.
- 11.
- 12.
- 13.
- 14.
- 15.
- 16.
- 17.
- 18.
- 19.
- 20.
- 21.
- 22.
- 23.
- 24.
- 25.
- 26.
- 27.
- 28.
- 29.
- 30.
- 31.
- 32.
- 33.
KRONİK BRONŞİT Bronşduvarında subepitelyal follikül oluşturan lenfosit infiltrasyonu, müköz glandlarda hiperplazi - 34.
- 35.
- 36.
- 37.
- 38.
- 39.
- 40.
- 41.
- 42.
- 43.
- 44.
- 45.
- 46.
- 47.
- 48.
- 49.
- 50.
- 51.
- 52.
- 53.
- 54.
- 55.
- 56.
- 57.
Asiner patern oluşturmuş,veziküle nüveli, nükleol belirginliği olan, eozinofilik, yer yer berrak sitoplazmalı adenokarsinom hücreleri - 58.
- 59.
- 60.
- 61.
- 62.
- 63.
- 64.
- 65.
- 66.
- 67.
- 68.
- 69.
- 70.
- 71.
- 72.